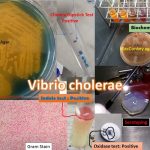

Tag: Cholera
Diarrhoea-Introduction, Types, Etiological Agent, Keynotes, and Further Readings
 Introduction of Diarrhoea Diarrhoea may be defined as increase infrequency, fluidity,...
Introduction of Diarrhoea Diarrhoea may be defined as increase infrequency, fluidity,...
Vibrio: Introduction, Morphology, Culture Characteristics, Pathogenesis, Lab Diagnosis and Treatment
Introduction of Vibrio Vibrios are Gram-negative, rigid, curved rods or...
Introduction of Vibrio Vibrios are Gram-negative, rigid, curved rods or...
